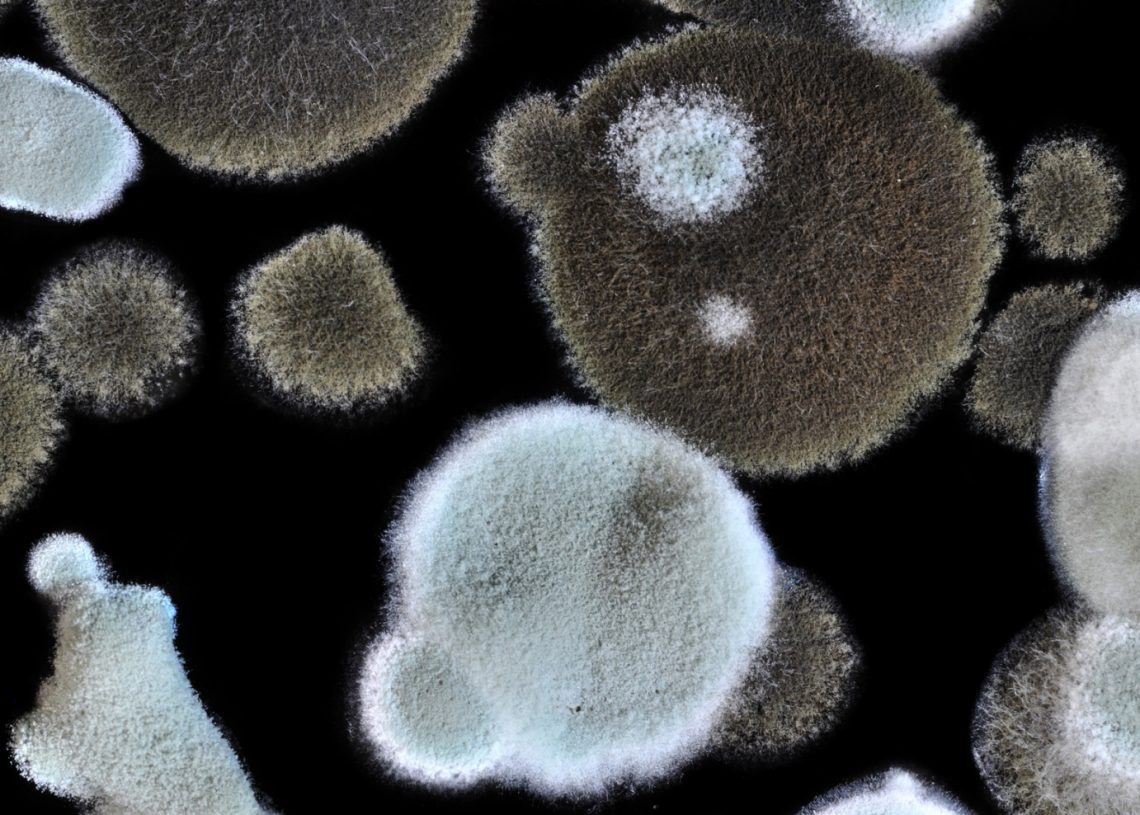
How Can You Benefit From The Services Of A Mold Remediation Company

Nothing is more upsetting than finding a spot of mold in your home when you least suspect it. Whether you’re expecting visitors this weekend or you’re concerned about health concerns, mold should be at the top of your home cleaning priority list.
Many individuals choose to remove it on their own, utilizing supermarket-purchased professionally made products and equipment. That’s a fantastic idea if you’re low on cash or have mold removal skills. Still, mostly it’s one of those jobs that professionals should handle. If you can handle the project on your own, then you should also have the right tools. Follow the link for more https://www.thespruce.com/how-to-get-rid-of-mold-4163846.
There are a few things to consider if you’re deciding between trying to remove mold manually and contacting expert remediation companies. We’ll go through the advantages of hiring this type of service for the safety of your home. Here’s what you need to know:
Satisfactory results

First of all, the most essential advantage of hiring a remediation company is the end result you will obtain. The outcomes you will obtain on your own vs. the results you may get from professional cleaners will differ dramatically for every house cleaning assignment you may have.
The experts will complete the task faster, faster, and more effectively than you because they are qualified and certified in this field and have years of knowledge. While DIY efforts are wonderful for things like oven cleaning, you should absolutely engage professional cleaners for anything as important (and potentially dangerous to your health) as mold eradication.
Tools and equipment

Another advantage of hiring an extermination service is that the professionals will have accessibility to all of the necessary tools and supplies. You can’t possibly eradicate a major infestation with random items strewn around the house: not only would they be useless, but they might also endanger your health! A poor attempt will just set you back more, so why spend time and effort when you can hire professionals and receive rapid, long-lasting results?
Mold removal is difficult at the best of circumstances, but did you even know that some types, such as black mold, may be extremely dangerous to your health and safety? Any touch or exposure to hazardous spores might result in significant health problems. Make sure to avoid doing that at all costs.
Cleaning businesses ensure that their employees go through a series of training courses, seminars, and licenses before being accredited as experts. This implies that the professionals have been scientifically and legally educated to handle even the deadliest mold varieties—something you can’t replace with enthusiasm or a do-it-yourself mentality! It’s safer to leave dangerous jobs like these to the professionals rather than risking your personal safety. Check out this page for more.
Tracking down the source

Mold infestations are usually discovered when people see obvious symptoms on their surfaces. It spreads rapidly, but by the time you detect it, it may have taken over your entire home. The spores also spread more quickly since they are transparent, light, as well as airborne.
You are probably aware that HVAC is an acronym for heating, ventilation, and air conditioning systems. The fungus grows in HVAC systems, tiles, under wallpaper, rugs, walls, and upholstery, among other places.
Finding the origin of the dampness is the most efficient approach to deal with it. Whenever you engage in a remediation business, the experts will come to your home and check it to find its cause. Experts will check the attic, ceiling, basement, bathroom, and kitchen, where it usually thrives.
Preventing the spread
The fungus has a reputation for spreading quickly. Within several weeks, it will influence every part of your home. It is impossible to stop it from spreading once it has entered your home. You could take a few steps to prevent them from spreading at first. But it isn’t enough to put a stop to them.
Remediation companies, on the other hand, utilize high-tech equipment to prevent spores from spreading. This equipment is very costly to purchase. Therefore, you should definitely consider professionals if you want to breathe clean and fresh air once more.
They also employ high-tech equipment to lower the humidity and temperature levels in your home. They will thoroughly clean the spots as well. They apply a sealer on the damaged areas to avoid moldy odors from expanding. Do you know what you should do? You need to check out Mold Near Me services to hire the right professionals for proper extermination!
Eliminating it entirely
Another significant benefit of hiring remediation services is removing the mold as soon as feasible. To avoid infection, you should leave your house for a few days after they’ve finished examining it. They will offer you a specific time frame for their removal.
During this period, the fungus will be removed from every area of your home by specialists from reputable remediation businesses. To minimize further contamination, they also wear protective suits. These specialists not only destroy the fungus but also clean the premises and repair any apparent mold damage.
Improved health
Mold is to blame for affecting the health of those who live in houses, apartments, and so on. The intensity of their attack is determined by how much human skin they have come into contact with. Heavy breathing, watery eyes, coughing, a stuffy nose, and headaches are possible side effects.
Hiring a reliable and professional remediation company is the only method to eliminate the presence of mold. You won’t have to worry about mold-related health problems once they’ve been removed.
Conclusion
As you can see, there are numerous and notable advantages to employing expert cleaning firms for mold removal. In truth, the majority of people’s reluctance originates from money worries. While professional mold cleaners are unquestionably costly, they may be less so than you think. After all, addressing a mold infestation as soon as possible is indeed an aesthetic as well as a health problem, so it makes sense to invest a little money now for long-term peace of mind.